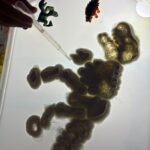
Papakia (2)

Πίνακας Παζλ “Δεινόσαυρος”
24.00€
Θεματικός πίνακας ο οποίος μπορεί να παιχτεί και ως παζλ και θα σας βοηθήσει να μάθετε και να συζητήσετε περισσότερα για αυτά τα αξιαγάπητα προς τα παιδιά ζώα .
***Ο κάδος Trofast ΔΕΝ συμπεριλαμβάνεται.
Θεματικός πίνακας με θέμα τον δεινόσαυρο . Είναι ένας πίνακας που μπορεί να παιχτεί και ως παζλ και θα σας βοηθήσει να μάθετε και να συζητήσετε περισσότερα για αυτά τα αξιαγάπητα προς τα παιδιά ζώα . Ακόμα, μπορεί να χρησιμοποιηθεί ο πίνακας σαν στένσιλ για τις χειροτεχνίες των μικρών σας .
Προτεινόμενη ηλικία :2 ετών+
Λεπτομέρειες προϊόντος : Αποτελείται από δυο μέρη , τον ξύλινο πίνακα και τα κομμάτια για να δημιουργήσετε τον δεινόσαυρο .
Καθαριότητα : Περάστε την επιφάνεια με υγρό πανί και σκουπίστε με ένα καθαρό στεγνό πανί.
Πρόταση παιχνιδιού : Βάψτε ρύζι στα αγαπημένα χρώματα του παιδιού και δώστε στο παιχνίδι μια πιο αισθητηριακή εμπειρία στη δημιουργία του δεινόσαυρου ή χρησιμοποιήστε το για να γίνετε αρχαιολόγοι και να ξεθάψετε τα μέρη του δεινοσαύρου .
***Ο κάδος Trofast ΔΕΝ συμπεριλαμβάνεται.
*Δεν είναι απαραίτητο να έχετε το Flisat τραπέζι του IKEA ή το τραπέζι Paignion για να το χρησιμοποιήσετε. Ένας κάδος Τrofsat του IKEA αρκεί .
| Αντικείμενο | Περιβάλλον |
|---|---|
| Ηλικία | 2 ετών +, 3 ετών +, 4 ετών +, 5 ετών + |
| Υλικό | Ξύλο |
| Μέγεθος Πίνακα | Μεγάλοι Πίνακες 39×27εκ |
Μπορεί επίσης να σας αρέσει…